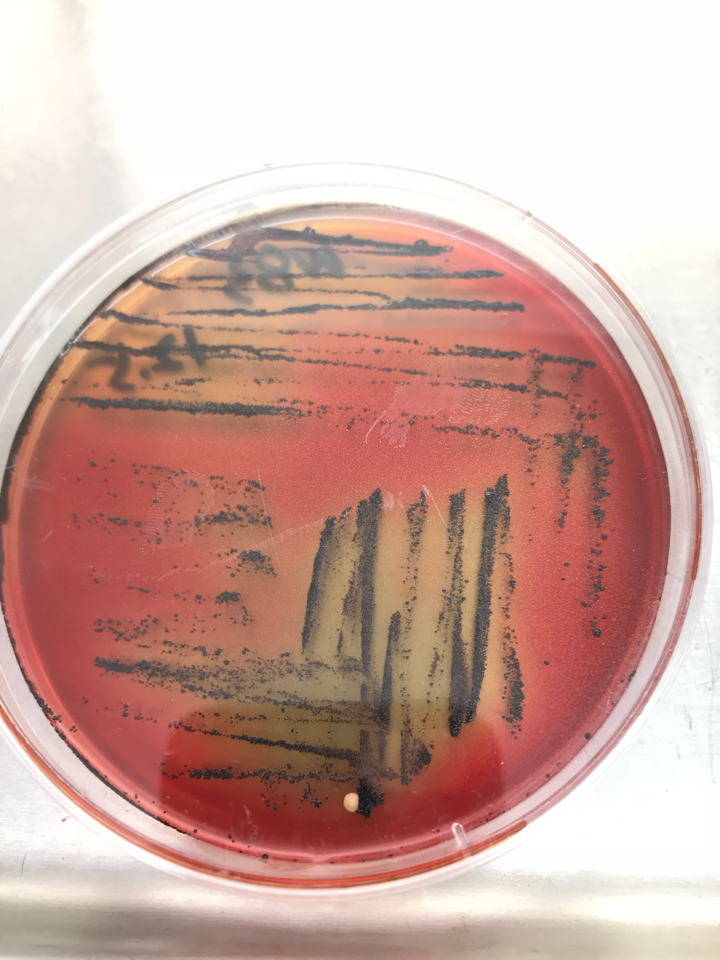
牙龈卟啉单胞菌的培养基? - 知乎

芽单胞菌门

运动发酵单胞菌_百度百科
图片尺寸268x163
荧光假单胞菌 - 搜狗百科
图片尺寸240x300
圣贝牙科教授告诉你牙周炎细菌侵入血液致老年痴呆,胃病,癌症统统找上
图片尺寸400x308
铜绿假单胞菌是什么菌?|细菌|杆菌_网易订阅
图片尺寸660x378
tg2蛋白在口腔病原体感染中发挥重要作用-行业新闻新闻中心|北纳生物
图片尺寸500x341
牙龈卟啉单胞菌是导致牙周炎的主要细菌病原体--中国中小企业河南网-
图片尺寸468x327
北京陆桥技术股份有限公司
图片尺寸996x516
假单胞菌_食品微生物检验二_食品检测技术_食品图库_食品伙伴网
图片尺寸480x346
pseudomonas aeruginosa 铜绿假单胞菌
图片尺寸1080x810
微生物培养芯片研究进展-技术前沿新闻中心|标物网
图片尺寸622x335
嗜水气单胞菌感染—搜狗搜索旗下的百科产品
图片尺寸448x373
丁香假单胞菌说明书-上海博湖生物科技有限公司
图片尺寸400x300
假单胞菌科图册_百度百科
图片尺寸180x220
北京陆桥技术股份有限公司
图片尺寸700x733
一株提高玉米耐盐能力的樊氏盐单胞菌菌株jpt10-1及其菌剂与应用的制
图片尺寸1000x969
牙龈卟啉单胞菌的培养基? - 知乎
图片尺寸720x960
萤光假单胞菌 - wikivisually
图片尺寸440x292
假单胞菌命名中的假单胞是什么意思? - 知乎
图片尺寸600x511
菌铜绿假单胞菌
图片尺寸1200x800
铜绿假单胞菌注射剂作用_绿脓杆菌_致病菌
图片尺寸600x375

.JPG/440px-Pseudomonas_fluorescens_on_TY_agar_(white_light).JPG)

